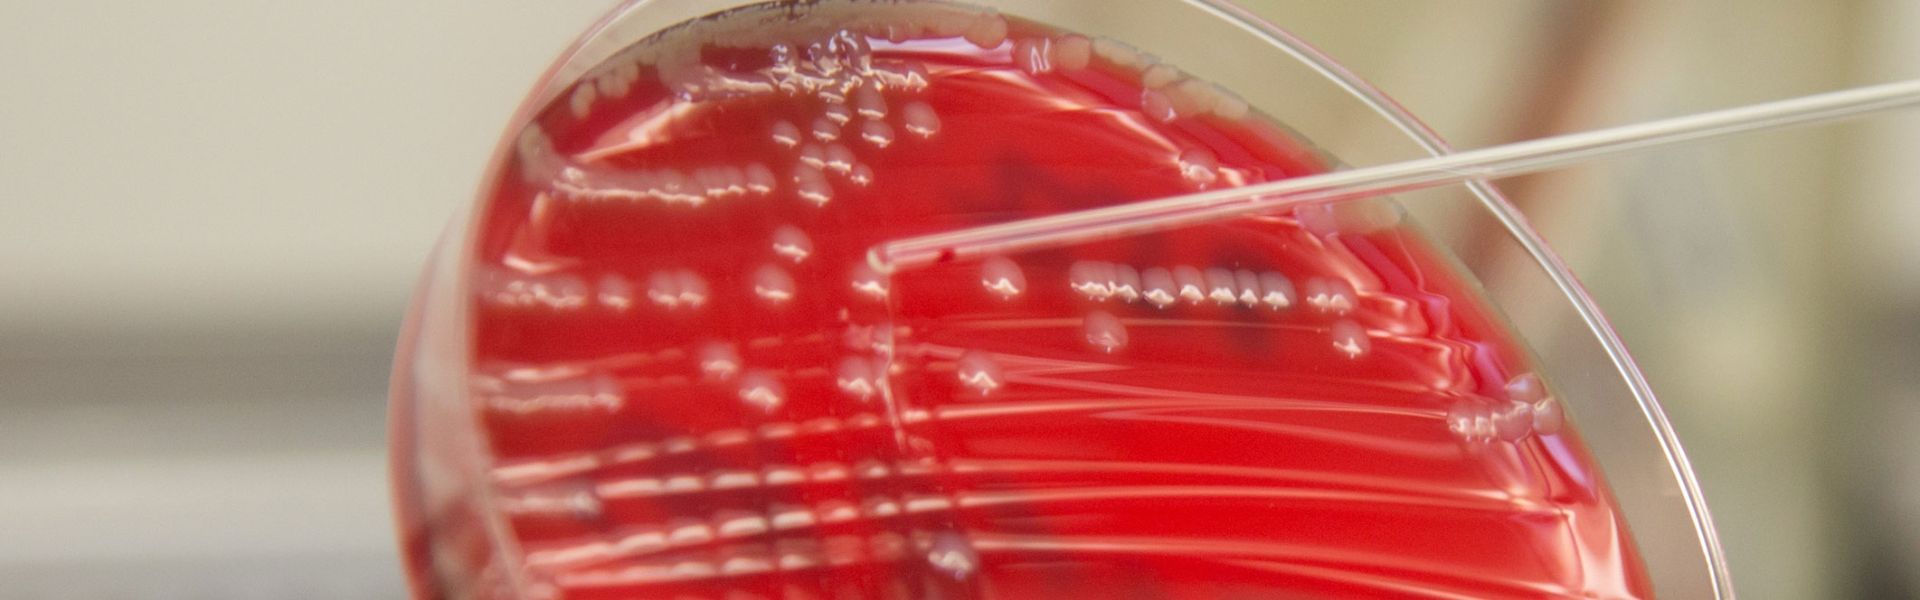

Qu’est-ce que la salmonellose et comment s’en prémunir ?
La salmonellose en chiffre
En France, en 2019, les salmonelles sont responsables de 39 % des cas de toxi-infections alimentaires collectives (TIAC) confirmées.
En Europe, les infections par des bactéries du genre Salmonella représentent la deuxième cause de maladies d’origine alimentaire. Toutefois, le nombre de foyers où ces bactéries ont été isolées est en constante diminution dans l’Union européenne depuis 2001. Cette amélioration reflète l’efficacité de la politique de l’Europe en matière de sécurité sanitaire des élevages et des abattoirs : abattage systématique des élevages de poules pondeuses contaminés, mesures d’hygiène tout au long de la chaîne de production.
Quelle source de contamination ?
Les animaux, y compris d’élevage, sont souvent porteurs asymptomatiques de cette bactérie sans pour autant être malades. Les déjections animales peuvent transmettre la bactérie à l’eau, aux végétaux ou à d’autres animaux par contact. Les aliments d’origine animale peuvent donc être contaminés et contaminer les environnements (cuisine, salle de préparation, atelier,..) et les personnes qui les manipulent (cuisinier, manutentionnaire,..).
Quels sont les aliments concernés ?
Les aliments crus ou insuffisamment cuits, surtout d’origine animale, sont les plus concernés : les oeufs et les produits à base d’oeufs crus, les viandes (bovines, porcines, incluant les produits de charcuterie crue, et de volailles), les fromages au lait cru.
D’autres aliments peuvent être sources de contamination, comme les végétaux, le lait en poudre pour les nourrissons, les fruits secs, le chocolat ou les céréales.
Les oeufs et les aliments à base d’oeufs crus (mayonnaise, crèmes, mousse au chocolat, tiramisu, etc.) sont à l’origine de près de la moitié des toxi-infections alimentaires collectives dues à Salmonella.
Quelles conséquences pour la santé ?
Salmonella peut provoquer une gastro-entérite aiguë qui se résout généralement spontanément en quelques jours.
Toutefois, les conséquences peuvent être graves chez certaines personnes qui peuvent présenter une sensibilité particulière, notamment les personnes :
- atteintes de malnutrition ;
- souffrant de certaines maladies (achlorhydrie, hypochlorhydrie ou maladie néoplasique) ou sous traitement contre l’acidité gastrique ;
- sous antibiothérapie à large spectre.
Chez les nourrissons ainsi que chez les personnes au système immunitaire affaibli (maladie auto immune, immunosuppressive, traitement médical immunosuppresseur, etc.), une infection par les salmonelles peut devenir très grave, voire mortelle.
Comment limiter notre exposition en tant que consommateur ?
- se laver les mains avec du savon en sortant des toilettes, avant la préparation et la prise des repas, et après avoir manipulé des denrées alimentaires crues ou non ;
- conserver les oeufs à température constante (soit toujours au frais, soit toujours à température ambiante), les oeufs ne doivent en aucun cas être lavés avant d’être stockés, le lavage permettant la migration des micro-organismes de l’extérieur de la coquille vers l’intérieur ;
- consommer les préparations à base d’oeufs crus sans délai après leur préparation ou maintenues au froid pour être consommées dans les 24h ;
- cuire à coeur (70 °C) les aliments d’origine animale, en particulier les viandes de porcs et de volailles et les viandes hachées ;
- il est recommandé aux personnes à risque de ne pas consommer d’oeufs crus ou peu cuits.
Quel est le rôle de l’Anses ?
- recueil de données sur les contaminations des animaux et des aliments, ainsi que dans l’environnement des élevages, des abattoirs et des ateliers de préparation des aliments dans le cadre de la surveillance officielle et du mandat national de référence qui lui a été confié pour cette famille de bactéries ;
- caractérisation des différentes souches et analyse des tendances d’évolution selon les sources de prélèvements, à travers le réseau Salmonella, dispositif national piloté par l’Anses. Ce réseau collecte des souches associées aux isolements de salmonelles d’origine animale, alimentaire et environnementale ;
- participation à l’investigation des foyers de salmonelloses humaines en lien avec la Direction générale de l’alimentation, Santé publique France et le Centre national de référence des Escherichia coli, Shigella et Salmonella (ESS) ;
- réalisation d’évaluations de risque sur l’ensemble de la chaîne alimentaire et identification des mesures les plus efficaces pour réduire le risque de salmonellose.
Date de mise en ligne
Numéro de saisine
Date de mise en ligne
Numéro de saisine
Date de mise en ligne
Numéro de saisine
Date de mise en ligne
Numéro de saisine
Date de mise en ligne
Numéro de saisine
Date de mise en ligne
Numéro de saisine
Date de mise en ligne
Numéro de saisine
Date de mise en ligne
Numéro de saisine
Date de mise en ligne
Numéro de saisine
Date de mise en ligne
Numéro de saisine
Date de mise en ligne
Numéro de saisine
Date de mise en ligne
Numéro de saisine
Date de mise en ligne
Numéro de saisine
Date de mise en ligne
Numéro de saisine
Date de mise en ligne
Numéro de saisine
Date de mise en ligne
Numéro de saisine
Date de mise en ligne
Numéro de saisine
Date de mise en ligne
Numéro de saisine
Date de mise en ligne
Numéro de saisine
Date de mise en ligne
Numéro de saisine
Date de mise en ligne
Numéro de saisine
Date de mise en ligne
Numéro de saisine
Date de mise en ligne
Numéro de saisine
Date de mise en ligne
Numéro de saisine
Date de mise en ligne
Numéro de saisine
Date de mise en ligne
Numéro de saisine
Date de mise en ligne
Numéro de saisine
Date de mise en ligne
Numéro de saisine
Date de mise en ligne
Numéro de saisine
Date de mise en ligne
Numéro de saisine


